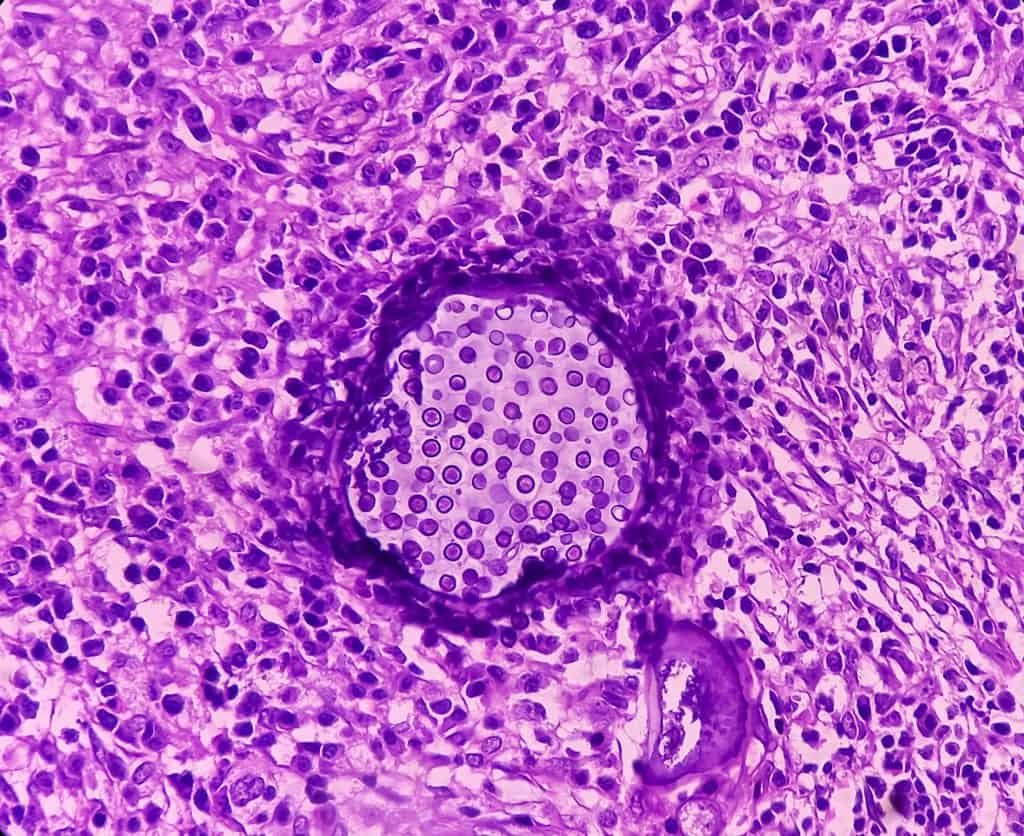

Što je upalni infiltrat
Što je upalni infiltrat
U medicini infiltrat označava nakupljanje tvari i stanica u tkivu koje se u normanom zdravom tkivu ne bi trebale nalaziti. Upalni infiltrat predstavlja nakupine prouzrokovane upalnim procesom čiji uzrok mogu biti bakterije, virusi, ali i tumorska tkiva. Upalni se infiltrati mogu pronaći u sluznici želuca, ali i u plućima, no najčešće se javljaju kao kronični gastritis u probavnom sustavu.
Obično se javljamo liječniku kada imamo bolove koji ne prestaju ili se javljaju periodično. Liječnik opće medicine će nas uputiti na pregled kod specijaliste koji će postaviti dijagnostiku i ustanoviti radi li se o situaciji kada se pojavi upalni infiltrat u vašem probavnom sustavu ili u plućima, iako se može pojaviti i u drugim organima.
Ovisno o uzroku upalnog procesa liječnik specijalista će propisati doze lijekova koji će izliječiti upalu i okloniti uzročnike upalnog procesa, te će se bolovi zbog kojih ste se javili liječniku smanjiti i potpuno nestati, što će biti znak da ste izliječeni.
Upalni infiltrat u probavnom sustavu
Upalni infiltrat u probavnom sustavu je upalni proces na sluznici želuca koji se javlja kao nakupina na sluznici. Ovakve nakupine uzrokuju probleme gastritisa koji je upala sluznice želuca. Najčešće je gastritis uzrokovan bakterijom Helicobacter pylori, no uzrok gastrisa mogu biti i korištenje nekih lijekova, zlouporaba alkohola, sustavne infekcije, intolerancija na neku hranu, postojanje žućnih kamenaca, te sindrom iritabilnog crijeva.
Gastritis se javlja kao akutni i kronični. Kod akutnog gastritisa problemi nastaju naglo, te traju kratko, no ako se ne liječi može postati kronični gastritis koji traje dulje vrijeme. Neliječeni kronični gastritis može izazvati nastanak čira, ulkusa, a može dovesti i do kobnog karcinom želuca.
Stoga upalni infiltrat čiji simptomi se javljaju kao bolovi u gornjem dijelu abdomena, slab apetit, umor, mučnine, povraćanja, nadutost i drugi probavni problemi koji nisu povezani uz obrok koji ste upravo pojeli svakako ne bi smjeli ignorirati. Naročito ako ovi simptomi traju dugo i ne prestaju svako trebate potražiti liječničku pomoć i liječenje.
Upalni infiltrat u plućima
Upalni infiltrat u plućima predstavlja pojavu uplanog procesa u plućima čemu postoje različiti uzroci. Ovakve se dijagnoze postavljaju na temelju RTG pluća jer su preko RTG snimke vidljive nakupine upalnog procesa u plućima. Upale pluća mogu biti tipične od poznatih uobičajenih bakterija, virus, pa i gljivica, do atipičnih upala pluća koje su uzrokovane ne tipičnim bakterijama poput Legionelle, Mycoplasme pneumoniae i drugih netipičnih bakterija koje nisu uobičajene i pojavljuju se rijetko.
Dijagnosticiranje radi li se o tipičnoj ili atipičnoj upali pluća teško se ustanovi, osim prema simptomima, moguće je dijagnostitcirati atipičnu upalu pluća uzrokovanu Legionellom koja se može ustanoviti testiranjem.
Upalni infiltrat će biti primjećen prilikom dijagnosticiranja RTG i bit će vidljivo da upalni proces obuhvaća zračne mjehuriće jednog ili i drugog plućnog krila. Uobičajeni simptomi zbog kojih trebate biti zabrinuti su suhi kašalj sa sluzi, a i gnojnim iscjetkom, groznica, temperatura i problemi prilikom disanja, te pomankanje daha. Osim bakterija, virusa, gljivica upalne procese mogu izazvati i kemijski utjecaji iz okoline kao što su pare i isparavanja štetnih tekućina i otrovnih plinova.
Tagovi:










